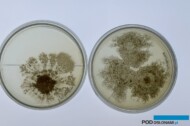
Trichoderma wchodzi w skład wielu nawozowych produktów mikrobiologicznych (for. DŁB)

W uprawie papryki i pomidora wapń należy do najważniejszych składników pokarmowych decydujących nie tylko o wielkości plonu, ale przede wszystkim o jego jakości handlowej, trwałości przechowalniczej oraz odporności roślin na stresy środowiskowe. Jego znaczenie bywa często niedoceniane, mimo że niedobory mogą prowadzić do poważnych strat ekonomicznych nawet przy prawidłowym nawożeniu pozostałymi makro- i mikroelementami. W [...] Czytaj dalej
Kategoria: nawożenie roślin ozdobnych

Nawożenie roślin ozdobnych – praktyczne wskazówki i sprawdzone nawozy z firmy Yara
Jednym z punktów programu przedsezonowego szkolenia w Igołomi (o którym pisaliśmy już na łamach portali PodOslonami.pl oraz HortiNet.pl) był wykład na temat nawożenia roślin ozdobnych. Klaudia Zamkowska, reprezentująca firmę Yara Poland, omówiła problemy nawożeniowe, wskazała również sposoby zapobiegania błędom w nawożeniu. Przedstawiła również specjalistyczne nawozy do wykorzystania w produkcji roślin ozdobnych. [...] Czytaj dalej

35 lat firmy BioGen – od pasji do innowacji w biotechnologii
Firma BioGen w 2025 roku obchodzi jubileusz swojej działalności. Z okazji 35-lecia zorganizowano duże wydarzenie dla mediów i osób związanych z biznesem na Atlas Arenie w Łodzi. Historia tego przedsiębiorstwa pokazuje, że dzięki dobrze dobranemu zespołowi można zdziałać wiele. Historia BioGen to opowieść o pasji, innowacji i nieustannym dążeniu do rozwoju, które uczyniły z niej jednego z czołowych graczy na rynku biotechnologicznym, zarówno w Polsce, jak i na świecie. Czytaj dalej

Czy biostymulator to to samo, co nawóz?
Wielu producentów zastanawia się, czy termin nawóz biostymulujący jest synonimem biostymulatora. Chociaż oba terminy są często używane zamiennie, istnieją między nimi istotne różnice, które warto rozważyć. Zarówno skład, jak i sposób rejestracji tych produktów różnią się w zależności od ich przeznaczenia i regulacji prawnych. Poniżej przedstawiam szczegóły i niuanse związane z tymi terminami, aby lepiej zrozumieć ich charakterystykę i zastosowanie. Czytaj dalej

Dlaczego kwasy humusowe są „must have” w uprawie gruntowej pod osłonami?
Intensywna produkcja warzyw i owoców w tunelach foliowych to dziś gospodarcza konieczność. Niestety użytkowana przez wiele lat ta sama działka stopniowo traci próchnicę, a z nią – zdolność do magazynowania wody, składników pokarmowych i korzystnych mikroorganizmów. Wynik? Słabszy start rozsady, zahamowany wzrost, większa podatność na stresy abiotyczne i niższy plon. Rozwiązaniem jest systematyczne [...] Czytaj dalej

Silver Mix i Silver Phos – skuteczna biostymulacja upraw pod osłonami
W intensywnych uprawach pod osłonami, takimi jak tunele foliowe, szklarnie czy daszki, producenci owoców i warzyw coraz częściej sięgają po rozwiązania wspomagające naturalną odporność roślin. Wysoka presja chorób grzybowych i bakteryjnych, gwałtowne zmiany temperatury i potrzeba maksymalizacji plonu sprawiają, że nawozy o właściwościach biostymulujących zyskują na znaczeniu. Silver Mix i Silver Phos, wyprodukowane w [...] Czytaj dalej

Maral – skuteczna biostymulacja roślin pod osłonami dla lepszego wzrostu i jakości plonu
W nowoczesnych technologiach upraw pod osłonami, gdzie stres środowiskowy ogranicza potencjał roślin, coraz większą rolę odgrywają biostymulatory. Maral to zaawansowany nawóz dolistny i do fertygacji, który wspiera zawiązywanie owoców, kwitnienie, wzrost roślin i poprawę jakości plonu, szczególnie w warunkach takich jak susza, nadmiar wody, niedobór światła czy wahania temperatury. Czytaj dalej

Uprawa warzyw i owoców zgodnie z naturą. Jaki nawóz wybrać?
Nawożenie warzyw i roślin owocujących jest konieczne, aby miały one dogodne warunki do rozwoju, a uprawy przyniosły odpowiednie plony. Jaki nawóz w ich przypadku jest potrzebny? Lepszym wyborem jest nawóz mineralny czy organiczny? Czytaj dalej

Regeneracja gleby pozwala zwiększyć efektywność nawożenia
Codzienność ogrodnika prowadzącego uprawy pod osłonami to wyścig z czasem i zmieniającymi się warunkami. Temperatura i wilgotność w tunelach foliowych ulegają dynamicznym wahaniom, a gleba, intensywnie eksploatowana, nie ma czasu na regenerację. Z biegiem lat traci próchnicę, zdolność do zatrzymywania wody oraz składników pokarmowych, co obniża jej żyzność i zwiększa zależność od nawozów mineralnych. Czytaj dalej

Fertygacja na najwyższym poziomie – sekrety sukcesu z nawozami Rosasol w uprawach pod osłonami
Profesjonalna fertygacja owoców i warzyw pod osłonami to klucz do uzyskania wysokich i stabilnych plonów przy jednoczesnej optymalizacji kosztów. Dzięki precyzyjnemu podawaniu wody i składników odżywczych bezpośrednio do strefy korzeniowej, rośliny mają stały i łatwy dostęp do niezbędnych składników pokarmowych, co przekłada się na wyższe przyrosty, szybszy wzrost oraz lepszą kondycję i jakość plonów. W ostatnich latach [...] Czytaj dalej

Alar 85 SG – profesjonalny regulator wzrostu dla upraw poinsecji i chryzantem
W uprawie roślin ozdobnych, szczególnie poinsecji i chryzantem doniczkowych, precyzyjna kontrola ich wzrostu i pokroju jest kluczowa, by osiągnąć wymagany wygląd roślin i zapewnić ich wysoką jakość. Aby sprostać tym wymaganiom, warto sięgnąć po skuteczny regulator wzrostu – Alar 85 SG. Produkt ten pomaga w uzyskaniu zwartych roślin o równomiernym wzroście i estetycznym pokroju, co jest niezbędne do osiągnięcia doskonałych rezultatów w uprawie roślin ozdobnych. Czytaj dalej
Mikroorganizmy w nawozach
W nawozowych produktach mikrobiologicznych można znaleźć szereg mikroorganizmów. Nawozowe produkty mikrobiologiczne zawierają mikroorganizmy (zarówno martwe, jak i nieaktywne) lub konsorcja tych mikroorganizmów oraz substancje stanowiące pożywkę dla tych mikroorganizmów i ich metabolity oraz nieszkodliwe substancje resztkowe z pożywek, które poprawiają aktywność biologiczną gleby lub stymulują procesy odżywiania roślin. Poniżej charakterystyka wybranych mikroorganizmów. Czytaj dalej

Wyciąg z drożdży dla zmęczonych gleb
Tym razem bierzemy pod lupę wyciąg z drożdży w uprawach pod osłonami. Papryka, pomidor oraz inne warzywa i rośliny jagodowe są gatunkami uprawnymi, które mają różne wymagania glebowe i klimatyczne. Ich zdrowy wzrost zależy m.in. od pH oraz zasolenia gleby. Odpowiednie nawożenie jest kluczowe, jednak można również napotkać problemy związane z glebą na zmęczonym stanowisku, gdzie przez lata nie stosowano płodozmianu oraz [...] Czytaj dalej

Preparaty mikrobiologiczne w rolnictwie i ochronie środowiska – II edycja wydarzenia w IUNG-PIB
Już 10 maja 2024 roku w Instytucie Uprawy Nawożenia i Gleboznawstwa – Państwowym Instytucie Badawczym w Puławach odbędzie się Konferencja pt. „Preparaty mikrobiologiczne w rolnictwie i ochronie środowiska”. Organizowana jest przez Zakład Mikrobiologii Rolniczej w ramach realizacji Dotacji Celowej 1.7 MRiRW. Minister Rolnictwa Czesław Siekierski objął wydarzenie patronatem honorowym. Czytaj dalej

Innowacyjne nawozy i biostymulatory – przegląd nowości wspomagających wzrost i rozwój roślin
Podczas minionych targów, m.in. TSW, które odbyły się na początku roku, mogliśmy dowiedzieć się jakie nawozy i biostymulatory polecane są obecnie do stosowania w uprawach ogrodniczych. Są wśród nich zarówno preparaty już dobrze sprawdzone w uprawach w warunkach Polski, jak nowości. W artykule zamieszczam krótką charakterystykę produktów z poszczególnych firm. Czytaj dalej

Od doniczek i nawozów po nowoczesne tunele i maszyny – agrotechniczne oblicze targów Gardenia 2023
Ubiegłoroczne targi Gardenia w Poznaniu były okazją do poznania nie tylko oferty roślin ozdobnych, ale także rozwiązań technicznych i środków produkcji. Wystawcy zaprezentowali wiele nowości, od nawozów i środków mikrobiologicznych – których oferta rośnie z roku na rok – po nowoczesne tunele foliowe. Mimo że główna oferta targów była adresowana do amatorów ogrodnictwa, także profesjonaliści mogli znaleźć tam coś dla siebie. Czytaj dalej

Wszystko do uprawy roślin ozdobnych (cz II). Nawozy.
Podczas niedawnych dni otwartych poświęconych odmianom roślin ozdobnych – balkonowo-rabatowych, bylin i ziół – można było także poznać ofertę firm oferujących środki produkcji. Były wśród nich m.in. firmy proponujące nawozy i biostymulatory. Poniżej krótki przegląd tego, co zaprezentowano w Zaborzu i w Gawartowej Woli do nawożenia lub wzmacniania i poprawy kondycji roślin. Czytaj dalej

Nawozy i biostymulatory polecane na nowy sezon – cz. II
Podczas targów ogrodniczych oraz licznych przed sezonem uprawy dni otwartych i seminariów mogliśmy poznać ofertę nawozów i biostymulatorów polecanych obecnie do stosowania w uprawach ogrodniczych. Są wśród nich zarówno preparaty już sprawdzone, jak i te mające niedawno swoją premierę. W kolejnych częściach przeglądu zamieszczamy krótką charakterystykę tej grupy środków produkcji ogrodniczej z poszczególnych firm (wymienionych w kolejności alfabetycznej). Czytaj dalej







